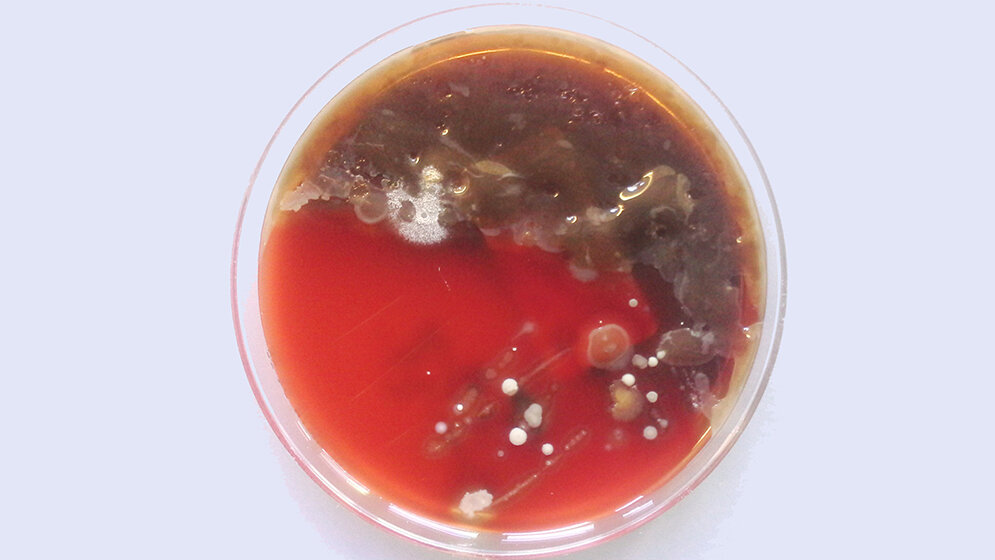
Pseudomonas aeruginosa

Ähnlich zum Darm sind die Lungen eine ökologische Nische für eine Vielzahl von Mikroorganismen, die teils noch unbekannt sind. Wenn diese Lebensgemeinschaft, das Mikrobiom, im Gleichgewicht ist, geht es dem Menschen gut. Nehmen jedoch schädliche Keime überhand, kann es zu Lungenentzündungen und Einschränkungen der Atemfunktion kommen. Doch die Frage ist, was zuerst da war: ein gestörtes Mikrobiom, das die Krankheitserreger durchgelassen hat oder führt eine chronische Infektion mit bestimmten Bakterien dazu, dass eine normale Lebensgemeinschaft verdrängt wird?
Diese Frage konnten Prof. Dr. Alexander Dalpke, stellvertretender Ärztlicher Direktor der Abteilung Medizinische Mikrobiologie und Hygiene, und Prof. Dr. Marcus A. Mall, Leiter des Mukoviszidose-Zentrums des Universitätsklinikums Heidelberg, nun beantworten. „Unsere Befunde zeigen, dass Mikrobiom-Veränderungen die Folge, nicht aber die Ursache einer Infektion mit dem Bakterium Pseudomonas aeruginosa sind“, sagt Dalpke. Die Wissenschaftler untersuchten hierfür wiederholt gewonnene Proben, in denen erstmalig oder regelmäßig das Bakterium Pseudomonas aeruginosa nachgewiesen wurde.
Die Proben wurden molekularbiologisch untersucht und stellten so die Mikrobiom-Zusammensetzung aufgrund von Gensequenzen fest. Klassischerweise werden Pseudomonas-Infektionen über Zellkulturen nachgewiesen. So konnten die Forscher Patienten unterscheiden und untersuchen, die chronisch, nur phasenweise oder noch gar nicht mit einer Pseudomonas-Infektion zu kämpfen haben. Das Bakterium Pseudomonas aeruginosa ist gefürchtet bei Patienten mit cystischer Fibrose, da es zu einem schnelleren Verlust der Lungenfunktion führt. Die Lunge der Patienten ist ein gut geeignetes Nährmedium für das Bakterium, da bei der cystischen Fibrose der Schleim in den Bronchien zähflüssiger ist als bei gesunden Menschen. Er kann vom Flimmerepithel nur schwer abtransportiert werden und die Bakterien können sich dort gut anreichern.
Chronische Pseudomonas-Infektionen können nur noch mit Antibiotika unterdrückt werden, weil sich die Bakterien adaptieren und in einem schützenden Biofilm verstecken. „Bei Erstinfektionen könnte sich eine aggressive Therapie mit Antibiotika lohnen, um die Patienten nicht nur vor einer chronischen Infektion mit Pseudomonas zu schützen, sondern auch um weitere Mikrobiom-Veränderungen zu vermeiden“, so Dalpke. „Von cystischer Fibrose betroffene Kinder bleiben bei frühzeitiger Bekämpfung einer Infektion länger Pseudomonas-frei und dies geht nach unseren Untersuchungen mit geringeren Veränderungen des Lungenmikrobioms einher.“
Insgesamt untersuchten die Forscher 392 Proben aus den Atemwegen von 71 Patienten, darunter auch Kleinkinder, von denen es bislang wenige Daten gab. Das Mikrobiom der Lunge kann aus über 100 verschiedenen Spezies bestehen. Diese können auch von Patient zu Patient stark variieren. Unklar ist jedoch, ob diese Mikroorganismen auch einen schützenden Effekt haben können. „Möglicherweise sind Mikroorganismen dieser Gruppe, zu denen zum Beispiel Bakterien der Gattungen Neisseria, Veillonella und Prevotella gehören, sogar mit besseren Lungenfunktionen assoziiert. Dies wird zurzeit kontrovers diskutiert und wird Thema weiterer Forschungsarbeiten sein“, so Dalpke. (idw, red)
Boutin S, Graeber SY, Stahl M, et al.: Chronic but not intermittent infection with Pseudomonas aeruginosa is associated with global changes of the lung microbiome in cystic fibrosis. Eur Respir J 2017 50: 1701086. DOI: 10.1183/13993003.01086-2017.
Artikel teilen